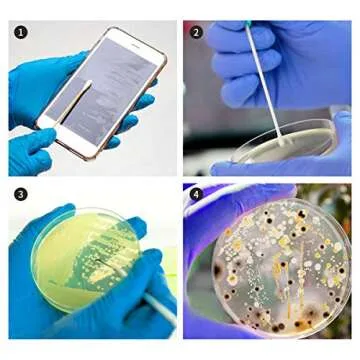
Bacteria Science Kit with Petri Dishes and Agar

Bacteria Science Kit: Petri Dishes, Agar & Swabs for STEM Fun!
- 41
- 0
- 100+ Sold in the past week
- 💥 300+ people added this to wishlists
- ⏳ Act fast — only a few left in stock
- ❤️ Loved by returning buyers






 Bathroom Storage & Organization
Bathroom Storage & Organization
 Laundry Storage & Organization
Laundry Storage & Organization
 Kitchen Storage & Organization
Kitchen Storage & Organization
 Clothing & Wardrobe Storage
Clothing & Wardrobe Storage
 Storage Baskets
Storage Baskets
 Storage Bags
Storage Bags
 Air Vacuum Bags
Air Vacuum Bags
 Portable Storage
Portable Storage
 Vacuum Bag Pumps
Vacuum Bag Pumps
 Portable Shopping Carts
Portable Shopping Carts
 Storage Holders & Racks
Storage Holders & Racks
 Storage Drawers
Storage Drawers
 Storage Boxes & Bins
Storage Boxes & Bins
 Storage Bottles & Jars
Storage Bottles & Jars
 Statues, Miniatures
Statues, Miniatures
 Decorative Accessories
Decorative Accessories
 Photo Frames, Boards
Photo Frames, Boards
 Clock
Clock
 Wind Chimes, Hanging Decorations
Wind Chimes, Hanging Decorations
 Painting, Calligraphy
Painting, Calligraphy
 Flags
Flags
 Banners, Accessories
Banners, Accessories
 Music Boxes
Music Boxes
 Candles, Holders
Candles, Holders
 Door Sticker
Door Sticker
 Christian Decor
Christian Decor
 Wall Stickers
Wall Stickers
 Flower Pots
Flower Pots
 Decorative Mirrors
Decorative Mirrors
 Plates, Signs
Plates, Signs
 Bedside Lamp, Lampshade
Bedside Lamp, Lampshade
 Decorative Lamp
Decorative Lamp

19.76
19.76

Introducing the Bacteria Science Kit – the ultimate hands-on experience designed to spark curiosity and excitement among young scientists! This comprehensive kit comes with all the essential tools needed to explore the fascinating world of microorganisms. Featuring pre-poured LB-Agar plates, cotton swabs, and petri dishes, it allows kids to easily cultivate and investigate bacteria in a safe and educational manner. Whether you're looking to engage a budding scientist or need a novel project...
Show moreIntroducing the Bacteria Science Kit – the ultimate hands-on experience designed to spark curiosity and excitement among young scientists! This comprehensive kit comes with all the essential tools needed to explore the fascinating world of microorganisms. Featuring pre-poured LB-Agar plates, cotton swabs, and petri dishes, it allows kids to easily cultivate and investigate bacteria in a safe and educational manner. Whether you're looking to engage a budding scientist or need a novel project for school, this kit makes a perfect choice while providing an unforgettable learning experience.
| manufacturer | DalosDream |
|---|---|
| color | Clear |
| height | 5 |
| weight | 1.10010668738 |
| width | 10 |
| length | 15 |
| productGroup | Toy |
The kit includes 10 pre-poured LB-Agar plates, cotton swabs, petri dishes, and detailed instructions for conducting experiments.
Yes, all materials are designed to be safe for children aged 6-10 when used under adult supervision.
It promotes STEM learning, critical thinking, and hands-on experimentation, making science fun and engaging!
Absolutely! The kit is perfect for science fair projects and encourages creative experimentation.
Follow local guidelines for disposing of biological materials, typically by sealing them in a bag and placing them in the trash.
 19.76
19.76

 Giftpals.com
Giftpals.com

